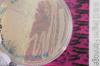
Evolving Molecules4

news
Designer Blood Clots: Artificial Platelets Could Treat Injured Soldiers on the Battlefield
Primary tabs
When it comes to healing the terrible wounds of war, success may hinge on the first blood clot – the one that begins forming on the battlefield right after an injury.
Researchers exploring the complex stream of cellular signals produced by the body in response to a traumatic injury believe the initial response – formation of a blood clot – may control subsequent healing. Using that information, they’re developing new biomaterials, including artificial blood platelets laced with regulatory chemicals that could be included in an injector device the size of an iPhone. Soldiers wounded in action could use the device to treat themselves, helping control bleeding, stabilizing the injury and setting the right course for healing.
Formation of “designer” blood clots from the artificial platelets would be triggered by the same factor that initiates the body’s natural clotting processes. In animal models, the synthetic platelets reduced clotting time by approximately 30 percent, though the materials have not yet been tested in humans.
“The idea is to have on the battlefield technologies that would deliver a biomaterial capable of finding where the bleeding is happening and augmenting the body’s own clotting processes,” said Thomas Barker, an associate professor in the Wallace H. Coulter Department of Biomedical Engineering at Georgia Tech and Emory University. “Simultaneously, the material would help instruct the biochemistry and biophysics of the clot structure that would govern subsequent healing.”
Barker presented information on the research Friday, Feb. 15 at the annual meeting of the American Association for the Advancement of Science (AAAS). The research has been sponsored in part by the National Institutes of Health (NIH), by the U.S. Department of Defense through the Center for Advanced Bioengineering for Soldier Survivability at Georgia Tech, and by an American Heart Association postdoctoral fellowship to Ashley Brown, a postdoctoral fellow working on the project.
After an injury, the most critical need is to stop the bleeding. But as traumatic injuries heal, they often produce significant scarring that is difficult to treat. Georgia Tech researchers are working on both sides of the problem, developing cell signaling techniques that may head off the formation of scars – as well as techniques for addressing the fibrosis that is often the long-term result. Beyond helping halt the bleeding, the synthetic platelets would deliver regulatory chemicals designed to prevent scarring.
“The blood clot actually ends up directing how the entire wound healing process is going to occur,” Barker said. “The initial clot matrix instructs very specific cellular behaviors which have consequences for the next wave of cells that comes in to do specific jobs, which have consequences for the next wave of cells. If we can modify that initial clot, it can become the three-dimensional matrix needed to build the regenerated or repaired tissue.”
The synthetic platelets, made from tiny structures known as hydrogels, could be injected into the bloodstream where they would circulate until activated by the body’s own clotting processes. Once activated, the particles – which are about one micron in diameter – would change shape, converting to a thin film that would help seal wounds. To develop these hydrogels, Barker is collaborating with Andrew Lyon, a professor in Georgia Tech’s School of Chemistry and Biochemistry.
The bloodstream contains proteins known as fibrinogen that are the precursors for fibrin, the polymer that provides the basic structure for natural blood clots. When they receive the right signals from a protein called thrombin, these precursors polymerize at the site of the bleeding. To prevent unintended activation of their synthetic platelets, the researchers use the same trigger.
The researchers followed a process known as molecular evolution to develop an antibody that could be attached to the hydrogels to cause their form to change when they encounter thrombin-activated fibrin. The resulting antibody has high affinity for the polymerized form of fibrin and low affinity for the precursor.
“We knew the molecule that we wanted and we knew the domains that were critical for recognition,” Barker said. “The primary design concept was the ability to recognize an active, forming clot from the soluble, inactive precursor.”
The artificial platelets have so far been tested in rats, and separately using in vitro simulated endothelial systems in the laboratory of Wilbur Lam, an assistant professor at Emory University in Atlanta. Though the work is a long way from a device that could be used on the battlefield, Barker envisions transitioning the research to a startup company that develop the technology to improve survivability for wounded soldiers.
“You could have it literally in the pocket of any soldier, who could pop it out when needed,” Barker explained. “As the needle is extended, you would break the package of freeze-dried particles. The device would then be placed on the abdomen, where the particles would be injected into the bloodstream. They would circulate inactive until they encountered the initiation of clotting.”
Once the bleeding was stopped, cytokines and anti-inflammatory compounds within the “designer” clot could help determine the phenotype that should be adopted by healing cells and regulate their behavior. That would set the stage for the subsequent healing process.
To help soldiers already suffering from the effects of fibrosis – the contraction of scarred tissue – the researchers are developing a polymer to which a natural peptide is attached. The peptide helps regulate the repair process that produces scars and could ultimately help reduce or reverse the effects of fibrosis. The technique has reversed the effects of pulmonary fibrosis in an animal model.
Though the research focuses on the needs of soldiers injured on the battlefield, many of the technologies could ultimately find civilian use. Because the artificial platelets would only activate when the encounter thrombin-activated fibrin, they could be used by emergency medical technicians treating patients in which internal bleeding is suspected, Barker said.
This research is supported by the National Institutes of Health (NIH) under contract R21EB013743 and by the U.S. Department of Defense (DoD) under contract W81XWH110306. The conclusions are those of the authors and do not necessarily represent the official views of the NIH or the DoD.
Research News
Georgia Institute of Technology
177 North Avenue
Atlanta, Georgia 30332-0181
Media Relations Contact: John Toon (404-894-6986)(jtoon@gatech.edu).
Writer: John Toon
Groups
Status
- Workflow status: Published
- Created by: John Toon
- Created: 02/14/2013
- Modified By: Fletcher Moore
- Modified: 10/07/2016
Categories
Keywords
User Data